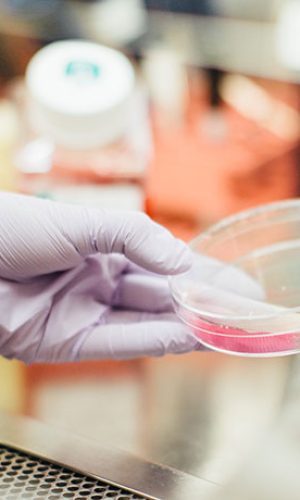
h1-wcu-img-2.jpg

Personale professionale ed empatico che si preoccupa di offrire un trattamento confortevole e di qualità.
I nostri medici eseguono periodici corsi di aggiornamento per offrire sempre le ultime terapie esistenti.
Siamo specializzati nella cura del viso e sorriso a 360° per soddisfare tutte le vostre esigenze.

Lo studio odontoiatrico Talarico si occupa del benessere del vostro viso e sorriso con personale che vanta esperienza da più di 25 anni.
Dopo un'attenta visita sapremo consigliarti quale sia il miglior trattamento possibile.
Lo studio odontoiatrico Talarico si specializza in diverse brache della medicina e chirurgia orale e facciale. Scopri tutti i trattamenti a disposizione.
I nostri medici ogni giorno si prendono cura con passione e professionalità dei nostri pazienti, studiando ogni singolo caso e suggerendo soluzioni su misura per il singolo caso.




Scegli il nostro studio per avere garanzia di massima professionalità, con tecniche e strumentazioni all'avanguardia che permettono di offrire performances altissime.
I nostri clienti confermano la loro fedeltà al nostro studio perchè sicuri di ricevere un trattamento d'eccellenza.
Grazie alle tecnologie digitali abbiamo portato al minimo il margine d'errore e ridotto l'invasività dell'intervento.








WhatsApp us